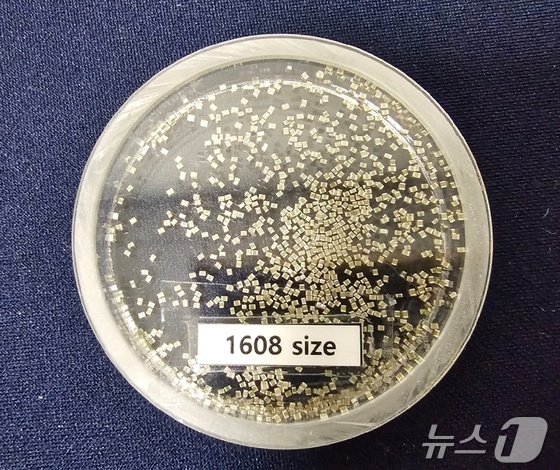

이재용 삼성전자 회장이 6일 필리핀 라구나주 칼람바시에 위치한 삼성전기 필리핀법인(SEMPHIL)을 찾아 MLCC 제품 생산현장을 점검하고 있다.(삼성전자 제공)
삼성전기(009150)가 지난해 4분기 영업이익 2395억 원을 기록하며 '어닝 서프라즈'를 올렸다. 시장 전망치(컨센서스)를 웃도는 깜짝 실적으로, 주력인 전자부품이 인공지능(AI) 산업 대호조에 힘입어 약진한 덕이다. 연간 매출도 11조 원을 돌파하며 신기록을 갈아치웠다.
"성수기급 서프라이즈"…연간 매출 '사상 최대'
삼성전기는 지난해 4분기 연결 기준 매출 2조 9021억 원, 영업이익 2395억 원을 잠정 기록했다고 23일 공시했다. 전년 동기 대비 매출은 16.4%, 영업이익은 108.2% 급증했다. 영업이익률은 8.2%이다. 순이익은 2273억 원으로 7.6% 증가했다.
연간 실적은 연결 기준 매출 11조 3145억 원, 영업이익 9133억 원으로 전년 대비 각각 9.9%, 24.3% 증가했다. 매출액은 창사 이래 최대 기록이다. 연간 순이익은 7310억 원으로 전년보다 3.9% 늘었다.
호실적은 적층세라믹커패시터(MLCC)와 플립칩-볼그리드어레이(FC-BGA) 등 주력 전자부품이 견인했다. 반도체부터 AI 데이터센터, 전장(차량용 전자·전기 장비), 로봇까지 시장 수요가 쏟아지면서 비성수기인 4분기도 '성수기급' 실적을 기록했다.
사업별로 보면 컴포넌트 부문은 지난해 4분기 매출은 연말 재고조정 등으로 전 분기보다 4% 감소했지만, AI·서버 및 파워용 MLCC 공급을 확대해 전년 동기보다 22% 늘어난 1조 3203억 원을 기록했다.
패키지설루션 부문의 4분기 매출은 전년 동기 및 전 분기보다 각각 17%, 9% 증가한 6446억 원을 기록했다. 글로벌 빅테크향 서버 및 AI 가속기용, 자율주행 시스템용 FC-BGA와 모바일 AP용 BGA 등 고부가 패키지기판 공급이 크게 확대된 영향이다.
광학설루션 부문의 4분기 매출은 전년 동기 대비 9%, 전분기 대비 2% 증가한 9372억 원을 기록했다. 삼성전기는 "고성능 IT용 차별화 카메라 모듈의 공급을 개시하고 글로벌 전기차 등 전장용 카메라 모듈 공급을 확대해 실적이 개선됐다"고 설명했다.
삼성전기의 적층세라믹콘덴서(MLCC)제품. 500cc 와인잔에 가득 채운 MLCC 가격은 3억 원에 달한다. 2024.10.30/뉴스1 © News1
'하이퍼-불' 올라탄 업황…글라스 기판·로봇도 노린다
올해 전망은 더 밝다. 글로벌 AI 산업이 하이퍼-불(초강세장)에 진입하면서 고부가 전자부품 수요도 더 가파르게 오를 전망이다. 삼성전기는 AI·전장 관련 고부가 제품 라인업을 강화하고, 시장이 개화하기 시작한 글라스(Glass) 기판과 휴머노이드 로봇용 부품 등 중장기 성장 기반을 구축한다는 계획이다.
컴포넌트는 AI 인프라 투자 지속 및 첨단운전자보조시스템(ADAS) 확산 영향으로 산업용 및 전장용 시장에서 수요가 지속 성장할 것으로 예상된다. 이에 삼성전자는 서버 및 네트워크 등 AI 및 산업용 고부가 제품 공급을 늘리고, 고용량·고압 등 전장용 MLCC 라인업을 강화해 전장 부문 매출을 확대할 계획이다.
패지지설루션도 데이터센터 시장 확대에 따른 AI·서버·네트워크 등 고부가 FC-BGA의 견조한 수요가 예상된다. 삼성전기는 신규 빅테크 고객향 AI가속기 및 네트워크용 패키지 기판을 공급해 매출을 확대하고, 하반기에는 생산 라인 풀가동에 대비해 공급 전략을 수립할 계획이다.
광학설루션은 전장용 ADAS 고도화 및 휴머노이드 등 신규 응용처 확대가 전망되고, 스마트폰용 카메라 고성능화 요구가 증가할 것으로 예상된다. 이에 삼성전기는 히터·발수코팅 등 전장용 특화품 공급 확대와 슬림·광학줌 등 차별화 기술이 적용된 스마트폰용 카메라 모듈 개발에 집중한다는 계획을 짰다.
나아가 피지컬 AI 시장에 선제적으로 대응하기 위한 고신뢰성 액추에이터 등 차세대 기술 확보도 추진할 계획이다.
dongchoi89@news1.kr










